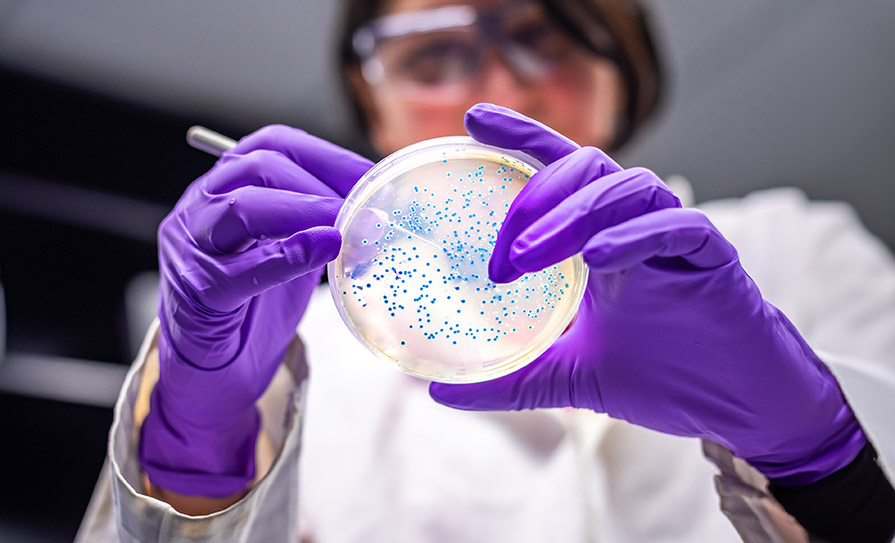

A “national approach” on reducing the high rate of verotoxin-producing E.coli (VTEC) infection is still being discussed, according to the Department of Agriculture, Food and the Marine (DAFM).
For several years, Ireland has had one of the highest VTEC notification rates in Europe, which have far exceeded the average.
In 2018, the crude incidence rate of VTEC was at its highest recorded level (23.4/100,000) but decreased to 18.3/100,000 in 2019. In 2022 it was 19/100,000, which was a 3 per cent increase on 2021, according to data from the Health Protection Surveillance Centre (HPSC).
Some 78 outbreaks were notified in 2022, an increase from 62 in 2021 but slightly below the typical numbers reported pre-pandemic.
“The number of VTEC outbreaks notified remained high in 2022 but the majority of outbreaks were small family outbreaks; childcare facilities remained the location where general VTEC outbreaks were most frequently notified,” according to the report Gastroenteric and Zoonotic Diseases in Ireland 2022 (HPSC, 2024).
In July 2019, the Chief Veterinary Officer wrote to the Chief Medical Officer about the “unacceptable” rate of human VTEC infection and the need for a ‘one health’ approach. Inter-agency discussions took place before the Covid-19 pandemic on developing a national action plan.
A DAFM spokesperson said the “national approach” is the subject of ongoing discussions with the Environmental Protection Agency, Food Safety Authority of Ireland, HSE, and other relevant partners.
These discussions are taking account of “changes in the public health system consequent to the public health reform programme and publication of the HSE’s National Health Protection Strategy 2022-2027”.
The main reservoir of VTEC is grass-feeding animals, in particular cattle, and Ireland has a high number of cattle per capita. The sizable proportion of people accessing private well water, and sensitive surveillance and laboratory systems, are believed to be factors contributing to the high national notification rate.
VTEC infection can cause gastroenteritis, enterocolitis, bloody diarrhoea and sometimes a life-threatening complication called haemolytic-uremic syndrome (HUS). Children and older people are particularly vulnerable to the effects of VTEC.
Some 980 cases were notified in 2022. There were 322 hospitalisations and 24 cases of HUS. See editorial

Leave a Reply
You must be logged in to post a comment.